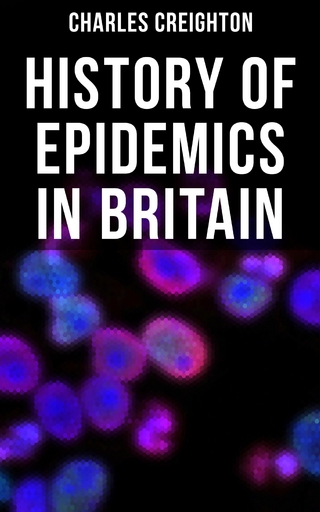
History of Epidemics in Britain

Tiefenpsychologisches Wissen für die psychiatrische Arbeit
Buch | Softcover
2020
|
Auflage:
1
|
Psychiatrie Verlag
ISBN: 9783884149386
CHF 41,95 (inkl. MwSt)
- Versand in
2-3 Tagen